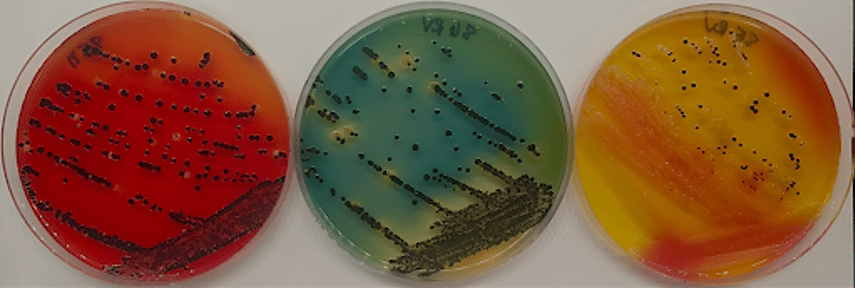

Bridging the gap between bioinformatics, microbiology, and molecular biology to study Salmonella dynamics in food animal production and the environment
Salmonella is a leading bacterial cause of foodborne illness in the United States and outbreaks are often linked to contamination of meat and poultry products, as well as fresh produce. Salmonella is represented by over 2,600 distinct serovars. This genetic diversity is responsible for providing Salmonella the ability to colonize a large variety of hosts and for different serovars to exhibit vastly different phenotypes.
Using novel next-generation sequencing tools combined with traditional microbiology, the Shariat Lab studies Salmonella ecology in food animal production and the environment. We seek to understand how different Salmonella serovars have a competitive advantage in certain animal hosts while others can survive different selective pressures that exist in the environment or in food production and processing.

The Shariat Lab is located in the Poultry Diagnostic & Research Center, one of four centers housed in the Department of Population Health at UGA’s College of Veterinary Medicine.
Our vision is that we are able to feed a growing global population safely, by improving surveillance and mitigation strategies to be faster and more accurate and also by understanding how pathogens work. We hope to be at the fore-front of developing technologies that enable us to address these goals, and that we’re able to answer fundamental questions about pathogen biology and microbial ecology to be able to reduce pathogen presence to improve food safety.
Our lab welcomes enthusiastic and motivated trainees at all levels – undergraduate, graduate, and postdoc researchers. We strive to maintain a cohesive and inclusive group where all members’ perspectives are considered.
Research in our lab bridges both basic and applied research. Understanding why Salmonella does what it does informs us on developing relevant and effective controls for this important pathogen. Most projects involve collaborations with industry, government researchers, and other academic groups at UGA and beyond. After leaving the lab, our trainees go on to fulfilling jobs in academia, industry, and government.
